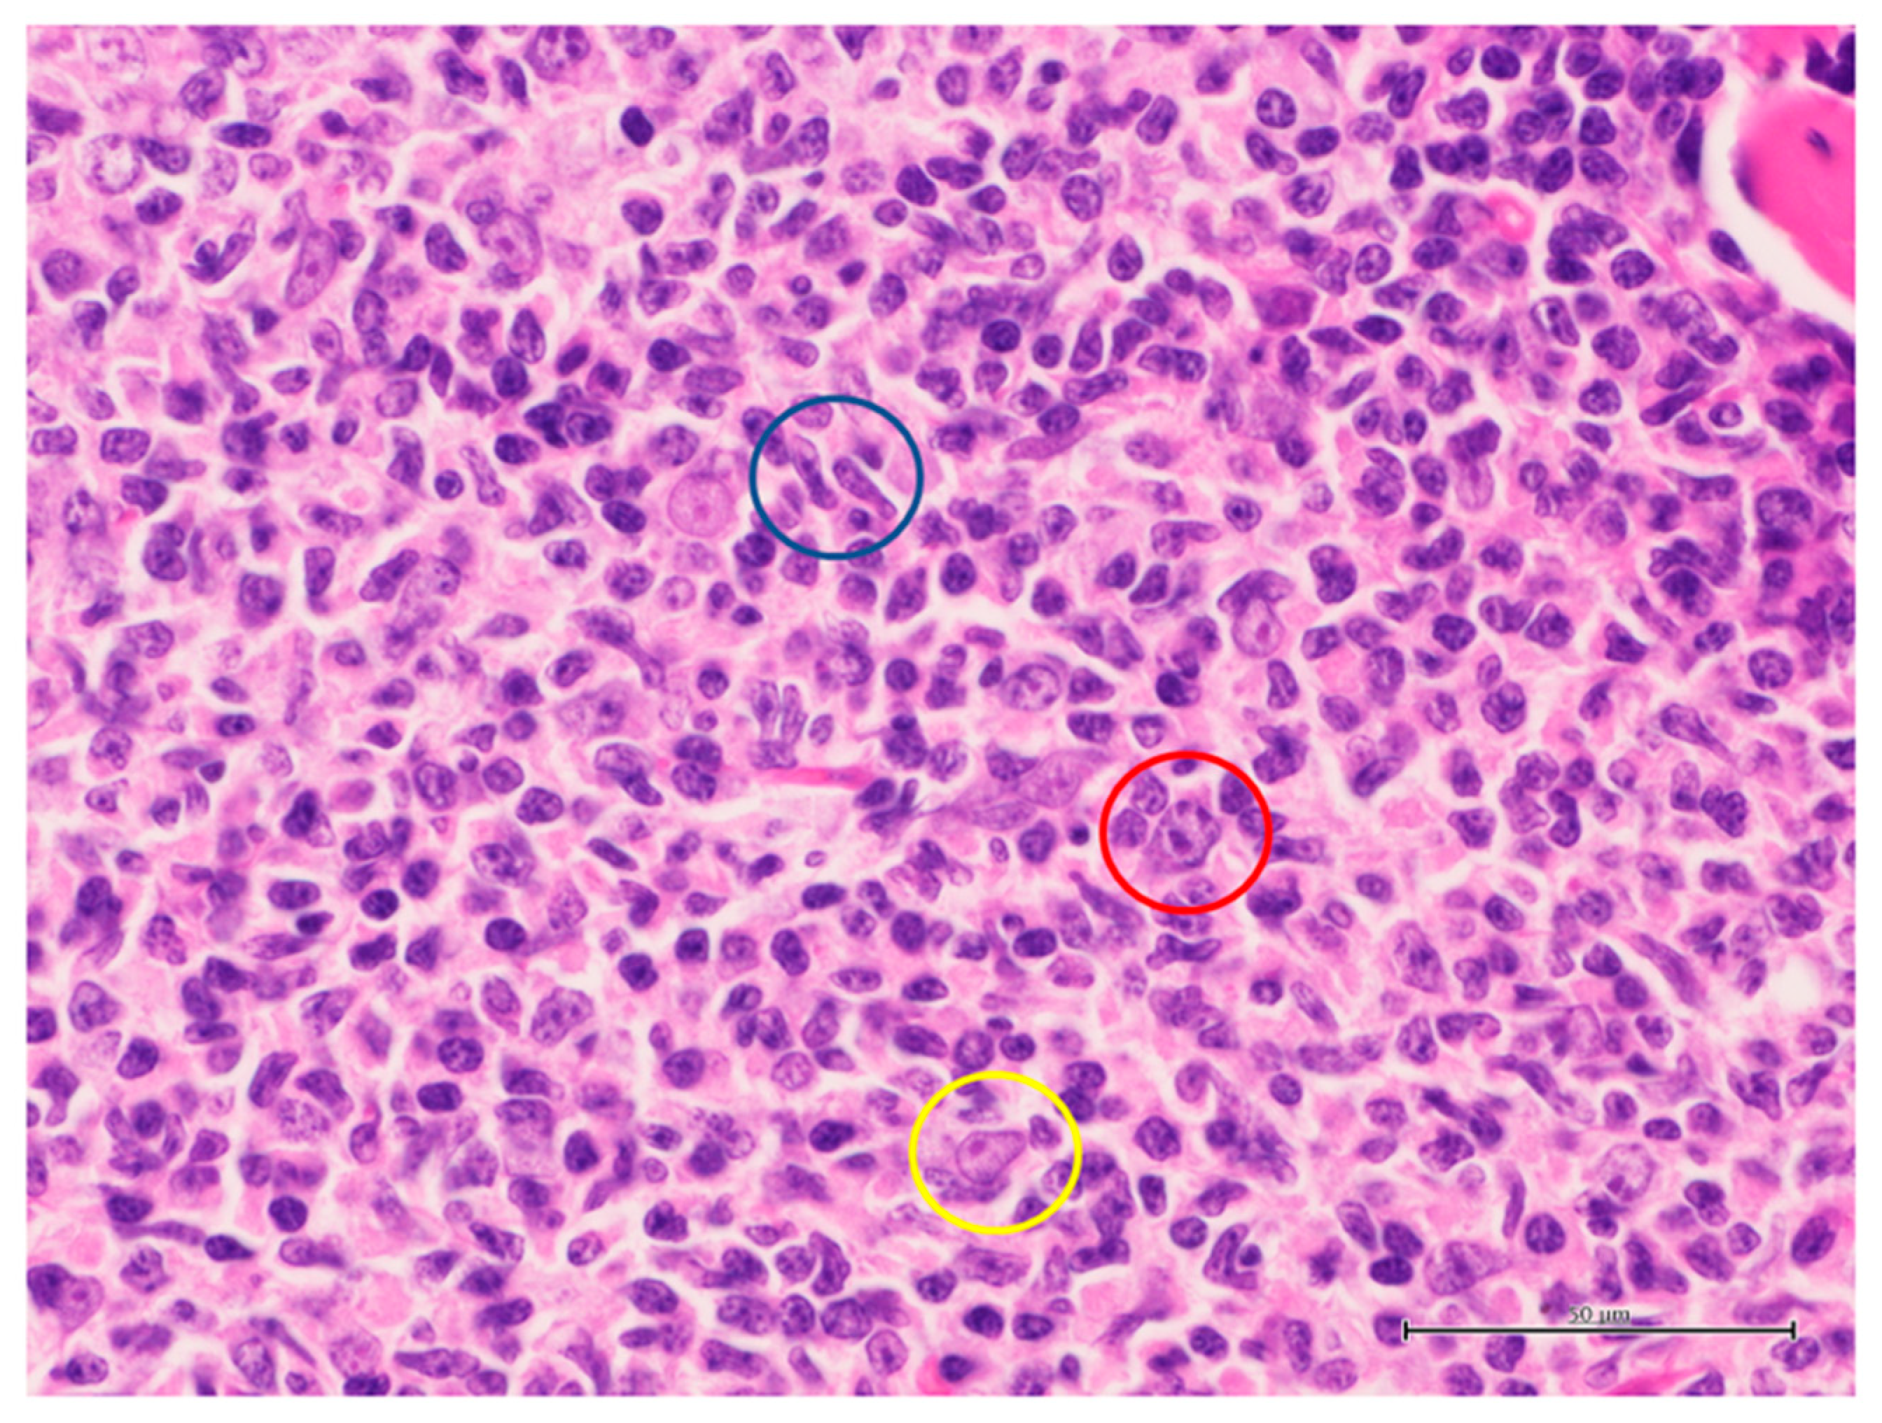
Ijms 24 06204 g003

Primary Cutaneous B-Cell Lymphomas with Large Cell Morphology: A Practical Review
Abstract
1. Introduction
2. Primary Cutaneous Diffuse Large B-Cell Lymphoma, Leg Type (PCDLBCL-LT)
2.1. Clinical Findings and Behavior
2.2. Histological Findings
2.3. Molecular Findings
3. Primary Cutaneous Follicle Centre Lymphoma (PCFCL)
3.1. Clinical Findings and Behavior
3.2. Histological Findings
3.3. Molecular Findings
4. Primary Cutaneous Diffuse Large B-Cell Lymphoma-Other (PCDLBCL-O): Primary Cutaneous Diffuse Large B-Cell Lymphomas Not Otherwise Specified (PCDLBCL, NOS)
4.1. Clinical Findings and Behavior
4.2. Histological Findings
4.3. Molecular Findings
5. Conclusions
Author Contributions
Funding
Institutional Review Board Statement
Informed Consent Statement
Data Availability Statement
Conflicts of Interest
References
- Sica, A.; Vitiello, P.; Sorriento, A.; Ronchi, A.; Calogero, A.; Sagnelli, C.; Troiani, T.; Fasano, M.; Dodaro, C.A.; Franco, R.; et al. Lymphomatoid papulosis. Minerva Med. 2020, 111, 166–172. [Google Scholar] [CrossRef] [PubMed]
- Sica, A.; Vitiello, P.; Ronchi, A.; Casale, B.; Calogero, A.; Sagnelli, E.; Costa Nachtigal, G.; Troiani, T.; Franco, R.; Argenziano, G.; et al. Primary cutaneous anaplastic large cell lymphoma (pcALCL) in the elderly and the importance of sport activity training. Int. J. Environ. Res. Public Health 2020, 17, 839. [Google Scholar] [CrossRef] [PubMed]
- Alaggio, R.; Amador, C.; Anagnostopoulos, I.; Attygalle, A.D.; Araujo, I.B.O.; Berti, E.; Bhagat, G.; Borges, A.M.; Boyer, D.; Calaminici, M.; et al. The 5th edition of the World Health Organization classification of haematolymphoid tumours: Lymphoid neoplasms. Leukemia 2022, 36, 1720–1748. [Google Scholar] [CrossRef] [PubMed]
- Swerlow, S.H.; Campo, E.; Harris, N.L.; Jaffe, E.S.; Pileri, S.A.; Stein, H. WHO Classification of Tumours of Haematopoietic and Lymphoid Tissues, revised, 3rd ed.; International Agency for Research on Cancer: Lyon, France, 2017; pp. 300–304. [Google Scholar]
- Vitiello, P.; Sica, A.; Ronchi, A.; Caccavale, S.; Franco, R.; Argenziano, G. Primary cutaneous B-cell lymphomas: An update. Front. Oncol. 2020, 10, 651. [Google Scholar] [CrossRef]
- Wilcox, R.A. Cutaneous B-cell lymphomas: 2016 update on diagnosis, risk-stratification, and management. Am. J. Hematol. 2016, 91, 1052–1055. [Google Scholar] [CrossRef]
- Sokol, L.; Naghashpour, M.; Glass, L.F. Primary cutaneous B-cell lymphomas: Recent advances in diagnosis and management. Cancer Control 2012, 19, 236–244. [Google Scholar] [CrossRef]
- Fava, P.; Roccuzzo, G.; Alberti-Violetti, S.; Grandi, V.; Pileri, A.; Pimpinelli, N.; Berti, E.; Quaglino, P. Cutaneous B-cell lymphomas: Update on diagnosis, risk-stratification, and management. Presse Med. 2022, 51, 104109. [Google Scholar] [CrossRef]
- Kraft, R.M.; Ansell, S.M.; Villasboas, J.C.; Bennani, N.N.; Wang, Y.; Habermann, T.M.; Thanarajasingam, G.; Lester, S.C.; Macon, W.; Inwards, D.J.; et al. Outcomes in primary cutaneous diffuse large B-cell lymphoma, leg type. Hematol. Oncol. 2021, 39, 658–663. [Google Scholar] [CrossRef]
- Schrader, A.M.R.; Jansen, P.M.; Vermeer, M.H.; Kleiverda, J.K.; Vermaat, J.S.P.; Willemze, R. High incidence and clinical significance of MYC rearrangements in primary cutaneous diffuse large B-cell lymphoma, leg type. Am. J. Surg. Pathol. 2018, 42, 1488–1494. [Google Scholar] [CrossRef]
- Menguy, S.; Frison, E.; Prochazkova-Carlotti, M.; Dalle, S.; Dereure, O.; Boulinguez, S.; Dalac, S.; Machet, L.; Ram-Wolff, C.; Verneuil, L.; et al. Double-hit or dual expression of MYC and BCL2 in primary cutaneous large B-cell lymphomas. Mod. Pathol. 2018, 31, 1332–1342. [Google Scholar] [CrossRef]
- Lucioni, M.; Pescia, C.; Bonometti, A.; Fraticelli, S.; Moltrasio, C.; Ramponi, A.; Riboni, R.; Roccio, S.; Ferrario, G.; Arcaini, L.; et al. Double expressor and double/triple hit status among primary cutaneous diffuse large B-cell lymphoma: A comparison between leg type and not otherwise specified subtypes. Hum. Pathol. 2021, 111, 1–9. [Google Scholar] [CrossRef] [PubMed]
- Zhou, X.A.; Louissaint, A., Jr.; Wenzel, A.; Yang, J.; Martinez-Escala, M.E.; Moy, A.P.; Morgan, E.A.; Paxton, C.N.; Hong, B.; Andersen, E.F.; et al. Genomic analyses identify recurrent alterations in immune evasion genes in diffuse large B-cell lymphoma, leg type. J. Investig. Dermatol. 2018, 138, 2365–2376. [Google Scholar] [PubMed]
- Koens, L.; Zoutman, W.H.; Ngarmlertsirichai, P.; Przybylski, G.K.; Grabarczyk, P.; Vermeer, M.H.; Willemze, R.; Jansen, P.M.; Schmidt, C.A.; Tensen, C.P. Nuclear factor-κB pathway-activating gene aberrancies in primary cutaneous large B-cell lymphoma, leg type. J. Investig. Dermatol. 2014, 134, 290–292. [Google Scholar] [CrossRef] [PubMed]
- Mareschal, S.; Pham-Ledard, A.; Viailly, P.J.; Dubois, S.; Bertrand, P.; Maingonnat, C.; Fontanilles, M.; Bohers, E.; Ruminy, P.; Tournier, I. Identification of somatic mutations in primary cutaneous diffuse large B-cell lymphoma, leg type by massive parallel sequencing. J. Investig. Dermatol. 2017, 137, 1984–1994. [Google Scholar] [CrossRef]
- Senff, N.J.; Zoutman, W.H.; Vermeer, M.H.; Assaf, C.; Berti, E.; Cerroni, L.; Espinet, B.; de Misa Cabrera, R.F.; Geerts, M.L.; Kempf, W.; et al. Fine-mapping chromosomal loss at 9p21: Correlation with prognosis in primary cutaneous diffuse large B-cell lymphoma, leg type. J. Investig. Dermatol. 2009, 129, 1149–1155. [Google Scholar] [CrossRef]
- Mitteldorf, C.; Berisha, A.; Pfaltz, M.C.; Broekaert, S.M.C.; Schön, M.P.; Kerl, K.; Kempf, W. Tumor microenvironment and checkpoint molecules in primary cutaneous diffuse large B-cell lymphoma-new therapeutic targets. Am. J. Surg. Pathol. 2017, 41, 998–1004. [Google Scholar] [CrossRef]
- Kodama, K.; Massone, C.; Chott, A.; Metze, D.; Kerl, H.; Cerroni, L. Primary cutaneous large B-cell lymphomas: Clinicopathologic features, classification, and prognostic factors in a large series of patients. Blood 2005, 106, 2491–2497. [Google Scholar] [CrossRef]
- Barasch, N.J.K.; Liu, Y.C.; Ho, J.; Bailey, N.; Aggarwal, N.; Cook, J.R.; Swerdlow, S.H. The molecular landscape and other distinctive features of primary cutaneous follicle center lymphoma. Hum. Pathol. 2020, 106, 93–105. [Google Scholar] [CrossRef]
- Zhou, X.A.; Yang, J.; Ringbloom, K.G.; Martinez-Escala, M.E.; Stevenson, K.E.; Wenzel, A.T.; Fantini, D.; Martin, H.K.; Moy, A.P.; Morgan, E.A.; et al. Genomic landscape of cutaneous follicular lymphomas reveals 2 subgroups with clinically predictive molecular features. Blood Adv. 2021, 5, 649–661. [Google Scholar] [CrossRef]
- Pileri, A.; Grandi, V.; Agostinelli, C.; Santucci, M.; Lastrucci, I.; Guglielmo, A.; Pipitò, C.; Pimpinelli, N. BCL-2 expression in primary cutaneous follicle center lymphoma is associated with a higher risk of cutaneous relapses: A study of 126 cases. J. Eur. Acad. Dermatol. Venereol. 2022, 36, e811–e813. [Google Scholar] [CrossRef]
- Franco, R.; Fernández-Vázquez, A.; Mollejo, M.; Cruz, M.A.; Camacho, F.I.; García, J.F.; Navarrete, M.; Piris, M.A. Cutaneous presentation of follicular lymphomas. Mod. Pathol. 2001, 14, 913–919. [Google Scholar] [CrossRef]
- Franco, R.; Fernandez-Vazquez, A.; Rodriguez-Peralto, J.L.; Bellas, C.; López-Ríos, F.; Sáez, A.; Villuendas, R.; Navarrete, M.; Fernandez, I.; Zarco, C.; et al. Cutaneous follicular B-cell lymphoma: Description of a series of 18 cases. Am. J. Surg. Pathol. 2001, 25, 875–883. [Google Scholar] [CrossRef] [PubMed]
- Servitje, O.; Climent, F.; Colomo, L.; Ruiz, N.; García-Herrera, A.; Gallardo, F.; Mercadal, S.; Pomares, H.; Muniesa, C.; Martin-Callizo, C.; et al. Primary cutaneous vs secondary cutaneous follicular lymphomas: A comparative study focused on BCL2, CD10, and t(14;18) expression. J. Cutan. Pathol. 2019, 46, 182–189. [Google Scholar] [CrossRef]
- Kim, B.K.; Surti, U.; Pandya, A.; Cohen, J.; Rabkin, M.S.; Swerdlow, S.H. Clinicopathologic, immunophenotypic, and molecular cytogenetic fluorescence in situ hybridization analysis of primary and secondary cutaneous follicular lymphomas. Am. J. Surg. Pathol. 2005, 29, 69–82. [Google Scholar] [CrossRef] [PubMed]
- Lawnicki, L.C.; Weisenburger, D.D.; Aoun, P.; Chan, W.C.; Wickert, R.S.; Greiner, T.C. The t(14;18) and bcl-2 expression are present in a subset of primary cutaneous follicular lymphoma: Association with lower grade. Am. J. Clin. Pathol. 2002, 118, 765–772. [Google Scholar] [CrossRef]
- Szablewski, V.; Ingen-Housz-Oro, S.; Baia, M.; Delfau-Larue, M.H.; Copie-Bergman, C.; Ortonne, N. Primary cutaneous follicle center lymphomas expressing BCL2 protein frequently harbor bcl2 gene break and may present 1p36 deletion: A study of 20 cases. Am. J. Surg. Pathol. 2016, 40, 127–136. [Google Scholar] [CrossRef] [PubMed]
- Ronchi, A.; Zito Marino, F.; Vitiello, P.; Caccavale, S.; Argenziano, G.; Crisci, S.; Franco, R.; Sica, A. A case of primary cutaneous B-cell lymphoma with immature features in an old man. Diffuse large B-cell lymphoma with immature features or B-cell lymphoblastic lymphoma? J. Cutan. Pathol. 2021, 48, 535–540. [Google Scholar] [CrossRef] [PubMed]
- Sica, A.; Vitiello, P.; Caccavale, S.; Sagnelli, C.; Calogero, A.; Doraro, C.A.; Pastore, F.; Ciardiello, F.; Argenziano, G.; Reginelli, A.; et al. Primary cutaneous DLBCL non-GCB type: Challenges of a rare case. Open Med. 2020, 15, 119–125. [Google Scholar] [CrossRef]
- Schrader, A.M.R.; de Groen, R.A.L.; Willemze, R.; Jansen, P.M.; Quint, K.D.; van Wezel, T.; van Eijk, R.; Ruano, D.; Tensen, C.P.; Hauben, E.; et al. Cell-of-origin classification using the Hans and Lymph2Cx algorithms in primary cutaneous large B-cell lymphomas. Virchows Arch. 2022, 480, 667–675. [Google Scholar] [CrossRef]
- Cretella, P.; Peluso, A.L.; Picariello, C.; Cozzolino, I.; Triggiani, M.; Puzziello, A.; Giudice, V.; Sabbatino, F.; Ieni, A.; Zeppa, P.; et al. Immunohistochemical algorithms and gene expression profiling in primary cutaneous B-cell lymphoma. Pathol. Res. Pract. 2022, 231, 153804. [Google Scholar] [CrossRef]
- Weissinger, S.E.; Dugge, R.; Disch, M.; Barth, T.F.; Bloehdorn, J.; Zahn, M.; Marienfeld, R.; Viardot, A.; Möller, P. Targetable alterations in primary extranodal diffuse large B-cell lymphoma. EJHaem 2022, 3, 688–697. [Google Scholar] [CrossRef] [PubMed]
- Vermaat, J.S.; Somers, S.F.; de Wreede, L.C.; Kraan, W.; de Groen, R.A.L.; Schrader, A.M.R.; Kerver, E.D.; Scheepstra, C.G.; Berenschot, H.; Deenik, W.; et al. MYD88 mutations identify a molecular subgroup of diffuse large B-cell lymphoma with an unfavorable prognosis. Haematologica 2020, 105, 424–434. [Google Scholar] [CrossRef] [PubMed]

| Histotype | Pathological Key Features | Helpful Finding | Diagnostic Molecular Tests |
|---|---|---|---|
| Primary cutaneous diffuse large B-cell lymphoma, leg type (PCDLBCL-LT) |
|
|
|
| Primary cutaneous follicle center lymphoma (PCFCL), follicular type |
|
|
|
| Primary cutaneous follicle center lymphoma (PCFCL), diffuse type |
|
|
| CD20 | CD3 | FDC | CD10 | Bcl6 | MUM1 | FOXP1 | CD5 | Bcl2 | Ki67 | |
|---|---|---|---|---|---|---|---|---|---|---|
| Prototype | + | few | absent | − | + (dim) | + | + | − | + | >50% |
| Other | + (dim) | − | − | − | − |
| CD20 | CD3 | FDC | CD10 | Bcl6 | MUM1 | FOXP1 | CD5 | Bcl2 | Ki67 | |
|---|---|---|---|---|---|---|---|---|---|---|
| Prototype | + | variable | +/− | +/− | + | − | − | − | − | <50% |
| Other | + | − | − | + | + | + | >50% |
Disclaimer/Publisher’s Note: The statements, opinions and data contained in all publications are solely those of the individual author(s) and contributor(s) and not of MDPI and/or the editor(s). MDPI and/or the editor(s) disclaim responsibility for any injury to people or property resulting from any ideas, methods, instructions or products referred to in the content. |
© 2023 by the authors. Licensee MDPI, Basel, Switzerland. This article is an open access article distributed under the terms and conditions of the Creative Commons Attribution (CC BY) license (https://creativecommons.org/licenses/by/4.0/).
Share and Cite
Ronchi, A.; Vitiello, P.; D’Abbronzo, G.; Caccavale, S.; Argenziano, G.; Sica, A.; Alfano, R.; Savarese, G.; Berretta, M.; Cozzolino, I.; et al. Primary Cutaneous B-Cell Lymphomas with Large Cell Morphology: A Practical Review. Int. J. Mol. Sci. 2023, 24, 6204. https://doi.org/10.3390/ijms24076204
Ronchi A, Vitiello P, D’Abbronzo G, Caccavale S, Argenziano G, Sica A, Alfano R, Savarese G, Berretta M, Cozzolino I, et al. Primary Cutaneous B-Cell Lymphomas with Large Cell Morphology: A Practical Review. International Journal of Molecular Sciences. 2023; 24(7):6204. https://doi.org/10.3390/ijms24076204
Chicago/Turabian StyleRonchi, Andrea, Paola Vitiello, Giuseppe D’Abbronzo, Stefano Caccavale, Giuseppe Argenziano, Antonello Sica, Roberto Alfano, Giovanni Savarese, Massimiliano Berretta, Immacolata Cozzolino, and et al. 2023. "Primary Cutaneous B-Cell Lymphomas with Large Cell Morphology: A Practical Review" International Journal of Molecular Sciences 24, no. 7: 6204. https://doi.org/10.3390/ijms24076204
APA StyleRonchi, A., Vitiello, P., D’Abbronzo, G., Caccavale, S., Argenziano, G., Sica, A., Alfano, R., Savarese, G., Berretta, M., Cozzolino, I., & Franco, R. (2023). Primary Cutaneous B-Cell Lymphomas with Large Cell Morphology: A Practical Review. International Journal of Molecular Sciences, 24(7), 6204. https://doi.org/10.3390/ijms24076204

